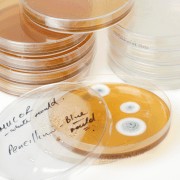
Mould In a Petrie dish Mould In a Petrie dish

H and V News Combating Legionella and Water Treatment Part 2
H and V News Conference 2016
Two weeks ago SAFESOL attended the H and V Combating Legionella Conference, and what an interesting few days it was. The write-up from the H and V News Conference will be split in to 2 parts. This blog will focus on part 2 with part 1 available to view here.
How North East Councils Tackle Legionella Control
Emma Jorgenson provided information on how Sunderland City Councils tackles Legionella control in their Academies. They ensure that these schools are aware of their obligations regarding legionella control, providing a valuable service to ensure they achieve compliance and providing training for all parties so that all members of staff are aware of the actions they have to take to prevent legionella bacteria in their buildings.
Jason O’Keeffe provided further information on how Lancashire County Council are striving to work more closely with their contractors to try and design out legionella control issues to ensure that problems are removed rather than controlled.

Legionella Control Issues In New and Refurbished Buildings
Caroline Vickers of Tetra Consulting also talked about the problems Estates teams have when they are handed over new or refurbished buildings. Initially, at handover they often do not meet compliance standards. They may already have legionella or pseudomonas issues because of the time delay in hand over or there may be dead legs left in place. In addition there may be too much stored water and there may be problems with heat gain in the cold water. Alternatively hot water temperatures can not be achieved. These should be simple problems to deal with but the longer they are left the more impact they have on budgets.
Solutions for New and Refurbished Buildings
Caroline had some simple solutions to problems such as filling and disinfecting a system as close to completion as possible. Once the system is filled ensure that regular weekly flushing of all outlets is carried out until the building is occupied. Also maintain equipment from point of installation. Also make sure that hot and cold pipe runs are not insulated together. This will ensure correct water temperatures are achieved in all areas. Systems must be properly balanced. In addition all removing deadlegs should be removed. and the amount of stored water reduced where possible.

aerosol created by a shower head.
Air Hygiene and Sick Building Syndrome
Paul Downing mixed it up by providing information on air hygiene and sick building syndrome. The cleaning of air hygiene units can be a major factor in preventing sick building syndrome. Air handling units, air conditioning unit and fan coil units should all be part of a legionella risk assessment. It is also important that these units are well insulated to prevent water contamination and the duct work is not “fogged with chemicals” as this treatment breaks down the galvanised coating of the ductwork. BSRIA BG57 provides information on this.
Responsibility
Next up was the debate on contractor’s and duty holder’s responsibilities. This echoed a lot of the information from throughout the day. The problems with legionella control start with the design stage of a building. Architects have poor legionella awareness when they design a building. They design for aesthetic effect and pay little attention to behind the scenes plant. This can lead to poor location of valves, over capacity water systems, and features such as showers being installed that fall out of use.
Plumbers then come and install the advised systems and they also have poor understanding of legionella control, leaving deadlegs in place as it is easier, insulating pipe work together, and using organic jointing compounds such as boss white and hemp which can provide nutrients for legionella and other bacteria to grow. The panel emphasised that there must be legionella training for designers and installers. This will prevent legionella issues in the first place. Prevention is always better than control.

Water pump
Hospital Infections
There was some very interesting information from Paul Jenkins regarding the other bacteria that can occur in hospital situations and is now causing disease. This included Mycobacterium chimaera that can be found in heater and cooler pumps for controlling blood temperature during operations. This bacterium gets into the machine at the time of manufacture.
Pseudomonas aeruginosa which is prevalent in domestic systems and has been linked with deaths in augmented care units. It requires more than engineering controls to prevent it. Also it requires a targeted approach in terms of engineering controls, best clinical and domestic practice.
Multi Resistant Super Bugs
There was also interesting information from the biologist Elise Maynard who provided information regarding the “Prevention and control of multi resistant super bugs”. These “superbugs” are resistant to at least 3 different anti biotics, estimated to cause 25,000 deaths and cost more than 1.5 billion dollars.
The World Health Organisation (WHO) action plan for super bugs is to
- Improve awareness and understanding of these superbugs
- Have more surveillance and research
- Reduce the incidence of infection
- Optimise the use of anti-microbial medicines
- To ensure sustainable investment
Examples of bacteria that are becoming resistant to antibiotics include: Legionella bacteria is also becoming resistant to the treatment fluoroquinolone. In a recent outbreak two patients who had Legionnaires’ disease did not get any better. Biofilm is also the enemy Legionella and amoeba association reduce the effectiveness of treatments.
Biofilm Resistance
Ralstonia Picketti has been identified in the biofilm in plastic pipes. It is capable of surviving in low nutrient concentrations. It can also survive in reverse osmosis units. This bacterium has led to outbreaks in patients with Cystic Fibrosis and Crohn’s disease. Mycobacterium avium is most resistant to chlorine disinfection.
Elizabethkingia Meningosectica lead to a 22-month ICU outbreak. The system had to be flushed 3 times daily which suggests that unfortunately, superbugs are becoming increasingly resistant to antibiotics, chemicals and temperature.
In Conclusion
The main themes from day one were that more education was required. People who are involved at the design and installation stage should have sufficient information and knowledge regarding legionella bacteria to carry out their job correctly. This can prevent problems occurring. Prevention is better than cure.

Roam Technology

